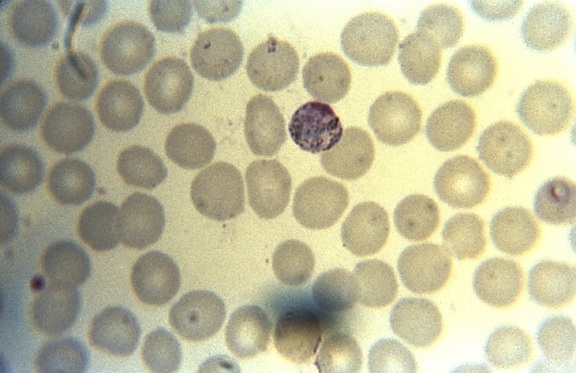

2023-24 TRM I year II Sem
- Docente: Cristian Colmo
- Docente: Giovanni Savini
2023-24 TRM I year II Sem
- Docente: Simona Superbi

2023-24 I year Annuale
- Docente: Daniela Bernardi
- Docente: Federica Catapano
- Docente: Cristian Colmo
- Docente: Laura Evangelista
- Docente: Stefano Figliozzi
- Docente: Marco Francone
- Docente: Ciro Franzese
- Docente: Carmela Galdieri
- Docente: Caterina Giannitto
- Docente: Lorenzo Leonardi
- Docente: Katia Marzo
- Docente: Massimiliano Paganini
- Docente: Stefano Sforzin
- Docente: Antonio Spinillo
- Docente: Simona Superbi
- Docente: Karima Tissir

2023-24 I year II Sem

2023-24 I year II Sem
- Docente: Franco Bottoni

2023-24 I year I Sem
- Docente: Franca Barbic
- Docente: Federica Collini
- Docente: Beatrice Mazzoleni
2023-24 I year II Sem
- Docente: Cristina Degiovanni
- Docente: Patricia Taylor
2023-24 I year I Sem
- Docente: Isabella Cinzia Barajon
- Docente: Sebastiano Bariselli
- Docente: Federica Catapano
- Docente: Antonietta Franco
- Docente: Caterina Giannitto
- Docente: Ezio Lanza

2023-24 I year I Sem
- Docente: Silvia Giugliano
- Docente: Stefania Vetrano

- "2023-24 I year I Sem "
- Docente: Pietro Mancosu
- Docente: Giovanni Savini